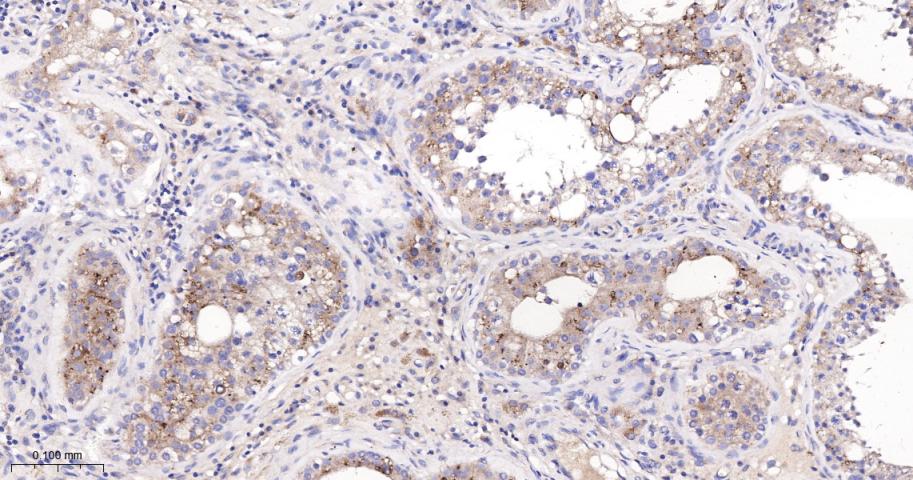
产品细节图片3

相关产品推荐更多 >
万千商家帮你免费找货
0 人在求购买到急需产品
- 详细信息
- 文献和实验
- 技术资料
- 应用范围:
产品信息以Bioss网站为准
- 规格:
50ul/100ul
| 规格: | 50ul | 产品价格: | ¥1180.0 |
|---|---|---|---|
| 规格: | 100ul | 产品价格: | ¥1980.0 |
| 产品编号 | bs-4960R |
| 英文名称 | Beta galactosidase Rabbit pAb |
| 中文名称 | β半乳糖苷酶抗体 |
| 英文别名 | BGAL_HUMAN; beta-galactosidase; GLB1; EC:3.2.1.23; Acid beta-galactosidase(Lactase); Elastin receptor 1; ELNR1; galactosidase beta 1; EBP; ELNR1; MPS4B; β-Galactosidase; β Galactosidase. |
| 产品应用 | WB=1:1000-2000, IHC-P=1:100-500, IHC-F=1:100-500, IF=1:100-500, ELISA=1:5000-10000, Flow-Cyt=1ug/Test Not yet tested in other applications. |
| 交叉反应 | Human, U-87MG |
| 抗体来源 | Rabbit |
| 免疫原 | Recombinant human GLB1 protein |
| 亚型 | IgG |
| 性状 | Liquid |
| 纯化方法 | affinity purified by Protein A |
| 克隆类型 | Polyclonal |
| 理论分子量 | 71 kDa |
| 浓度 | 1mg/ml |
| 储存液 | 0.01M TBS (pH7.4) with 1% BSA, 0.02% Proclin300 and 50% Glycerol. |
| 亚细胞定位 | Isoform 1: Lysosome. Isoform 2: Cytoplasm, perinuclear region. Note=Localized to the perinuclear area of the cytoplasm but not to lysosomes. |
| 相似性 | Belongs to the glycosyl hydrolase 35 family. |
| 功能 | Cleaves beta-linked terminal galactosyl residues from gangliosides, glycoproteins, and glycosaminoglycans.
Isoform 2 has no beta-galactosidase catalytic activity, but plays functional roles in the formation of extracellular elastic fibers (elastogenesis) and in the development of connective tissue. Seems to be identical to the elastin-binding protein (EBP), a major component of the non-integrin cell surface receptor expressed on fibroblasts, smooth muscle cells, chondroblasts, leukocytes, and certain cancer cell types. In elastin producing cells, associates with tropoelastin intracellularly and functions as a recycling molecular chaperone which facilitates the secretions of tropoelastin and its assembly into elastic fibers. |
| 保存条件 | Shipped at 4℃. Store at -20℃ for one year. Avoid repeated freeze/thaw cycles. |
| 注意事项 | This product as supplied is intended for research use only, not for use in human, therapeutic or diagnostic applications. |
| 背景资料 | This gene encodes a member of the glycosyl hydrolase 35 family of proteins. Alternative splicing results in multiple transcript variants, at least one of which encodes a preproprotein that is proteolytically processed to generate the mature lysosomal enzyme. This enzyme catalyzes the hydrolysis of a terminal beta-linked galactose residue from ganglioside substrates and other glycoconjugates. Mutations in this gene may result in GM1-gangliosidosis and Morquio B syndrome. [provided by RefSeq, Nov 2015] |
| 应用 | 推荐稀释比例 |
| {WB} | {1:1000-2000} |
| {IHC-P} | {1:100-500} |
| {IHC-F} | {1:100-500} |
| {IF} | {1:100-500} |
| {ELISA} | {1:5000-10000} |
| {Flow-Cyt} | {1ug/Test} |

风险提示:丁香通仅作为第三方平台,为商家信息发布提供平台空间。用户咨询产品时请注意保护个人信息及财产安全,合理判断,谨慎选购商品,商家和用户对交易行为负责。对于医疗器械类产品,请先查证核实企业经营资质和医疗器械产品注册证情况。
文献和实验[IF={{ 4.138 }}] {Yang et al. RANKL deletion in periodontal ligament and bone lining cells blocks orthodontic tooth movement. (2018) Int.J.Oral.Sci. 10:3} {IF} {mouse}
[IF={{ 14.079 }}] {Zagory JA et al. PROMININ‐1 promotes biliary fibrosis associated with biliary atresia. Hepatology. 2019 Feb 5.} {IF,IHC} {Mouse}
Studies of the Ubiquitin Proteasome System
Assays of E1 and E2 Activity Basic Protocol 1: Thiolester Formation Between Rabbit E1 and Ubiquitin Basic Protocol 2: Thiolester Formation Between E2 and Ubiquitin Binding of Ubiquitin‐Proteasome Proteins Basic Protocol 3: Binding of E2s to E3s Alternate
Generation of Spatio‐Temporally Controlled Targeted Somatic Mutations in the Mouse
of CreERT2. J. Immunol. 182:5633‐5640. Huelsken, J., Vogel, R., Erdmann, B., Cotsarelis, G., and Birchmeier, W. 2001. Beta‐Catenin controls hair follicle morphogenesis and stem
技术资料暂无技术资料 索取技术资料









